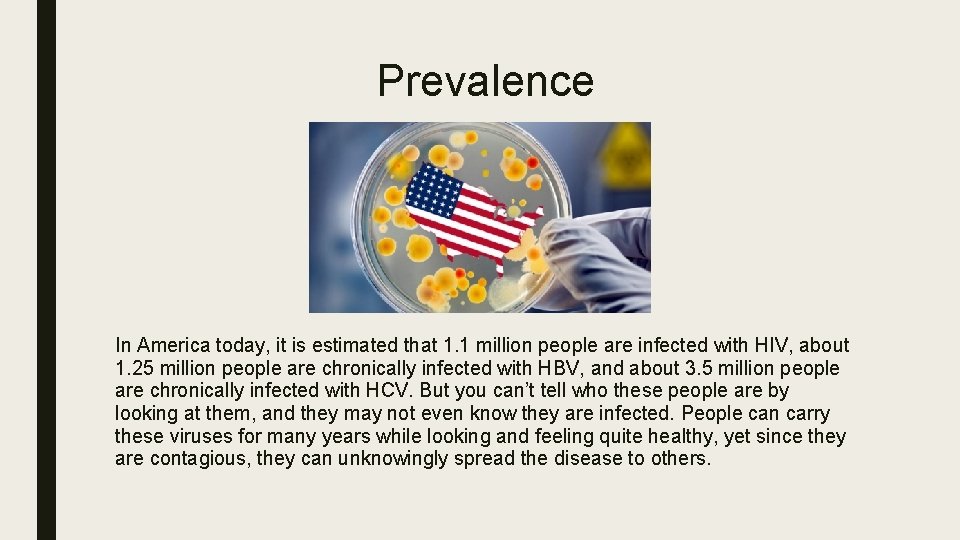
Prevalence In America today, it is estimated that 1. 1 million people are infected

BLOODBORNE PATHOGENS KNOW THE RISKS Introduction You along

BLOODBORNE PATHOGENS KNOW THE RISKS!!!

Introduction You, along with most people today, have probably heard a lot about AIDS and other bloodborne diseases. You may have wondered about your own risk on the job, especially if someone you work with gets hurt. In this training, we will review bloodborne diseases, your risk of exposure on the job, and the simple measures you can take to protect yourself against exposure.

AIDS, Hepatitis B, and Hepatitis C The most common bloodborne diseases which you could be exposed to on the job include AIDS, or Acquired Immune Deficiency Syndrome, Hepatitis B virus, and Hepatitis C virus.

AIDS/HIV AIDS is a serious illness caused by the Human Immunodeficiency virus (HIV). The virus attacks a person’s immune system and causes it to break down. Some people develop AIDS. The number of HIV-infected people who develop serious illnesses and die from AIDS is decreasing due to recent treatments and advancements in antiretroviral therapy (ART), but there is no vaccine to prevent HIV infection. The only preventative option is Pre. Exposure Prophylaxis (Pr. EP).

Hepatitis B (HBV) Hepatitis B is a viral infection that affects the liver. Unlike HIV, hepatitis B can often be treated successfully. In fact, a vaccine is available to help protect you against getting the hepatitis B virus. * Yet unless you are effectively vaccinated, hepatis B is a bigger threat to you than HIV because it is much more common. If you become infected with HBV, you may just feel like you have the flu. Or you may be so sick you have to be hospitalized. Each year, more than 5, 000 people in the USA die from the chronic liver disease this virus can cause. *CCS will reimburse any employee for the cost of getting a Hep B vaccination if they complete the vaccine schedule while employed with CCS

Hepatitis C (HCV) Like hepatitis B, hepatitis C also affects the liver. However unlike hepatitis B, hepatitis C can only be contracted through blood-to-blood contact, which can happen through sharing needles, childbirth, or blood transfusions and organ transplants that occurred before 1992. HCV is also more likely than HBV to become a chronic condition. There is no vaccine for HCV like there is for HBV, but ever since 2013, doctors have been able to prescribe antiviral medications to treat HCV.
Prevalence In America today, it is estimated that 1. 1 million people are infected with HIV, about 1. 25 million people are chronically infected with HBV, and about 3. 5 million people are chronically infected with HCV. But you can’t tell who these people are by looking at them, and they may not even know they are infected. People can carry these viruses for many years while looking and feeling quite healthy, yet since they are contagious, they can unknowingly spread the disease to others.

Transmission of Bloodborne Diseases HIV, HBV, and HCV are primarily spread by three types of bodily fluids: blood, vaginal secretions, and semen. These viruses can also be passed from pregnant women to their children before, during, or after birth. For someone to actually get infected by one of these viruses, blood or other body fluids containing the virus must get inside this person’s body and enter the bloodstream through a break in the skin or through the mucous membranes. This most commonly happens when a person has sex with an infected person or by sharing needles to inject drugs. During sex, the virus can enter the body through the mucous membranes of the sexual organs, mouth, or rectum. When people share needles, the virus can enter the body if the skin is punctured by a contaminated needle. HIV in particular is a fragile virus. Unless it is kept under controlled laboratory conditions, it cannot survive away from a person’s body fluids. After years of study, researchers have found that none of the family members, friends, or caregivers of people with AIDS have ever become infected through casual contact.

Bloodborne Pathogen Transmission in the Workplace HIV, HBV, and HCV are only transmitter in the workplace when there in contact between broken skin or mucous membranes and infected blood. Most of the workplace situations people tend to worry about are actually quite harmless. HIV, HBV, and HCV are not spread through the air like cold and flu germs, so you will not be infected by these viruses from: ■ Working along side someone who is infected or from touching, social kissing, coughing, or sneezing ■ Sharing things such as telephones or bathrooms with an infected person ■ Using eating utensils, water fountains, gym equipment, or swimming pools

The chance of you being infected by a bloodborne virus in your workplace is slim. However, since HIV, HBV, and HCV may be present in any blood or body fluids that are visibly contaminated with blood, exposure is possible. These viruses may get inside your body if blood or body fluids contact your eyes, nose, mouth, or breaks in your skin. Your skin acts as a protective barrier to keep viruses out, unless broken by cuts, scrapes, sores, dermatitis, acne, or other injury.

Precautions You Can Take To prevent exposure to these viruses, precautions should be taken in all settings – including the workplace – to prevent contact with blood or other potentially infectious materials.

PRECAUTION: Preventative Housekeeping Surfaces soiled with blood and body fluids should be disinfected appropriately. Unlike HIV, HBV is very hardy and can survive on environmental surfaces, dried and at room temperatures, for at least one week. Cleaning personnel may come in contact with potentially infectious substances while performing routine cleaning or maintenance tasks. These substances can be anywhere they have to clean such as countertops, toilets, sinks, or trash cans. Cleaning personnel should always be prepared by wearing gloves and a protective smock or apron on the job. If your duties include cleaning, do not attempt to clean spills of blood or other body fluids unless you are trained and authorized to do so. Contact authorizes cleaning personnel and block off the area until they arrive.

Spills should be covered with disposable paper towels to prevent fluid from spreading and then cleaned up with a germicidal cleaning agent. Be alert for sharp objects such as broken glassware or used syringes when emptying trash containers. Always use a brush and dust pan, tongs, or forceps to pick up broken glassware – NOT your hands. Place contaminated sharp objects and other contaminated wastes or cleaning materials in sturdy, leak-proof containers and dispose of according to your company policy.

PRECAUTION: Preventative Handwashing Always wash your hands thoroughly and promptly after contact with blood or body fluids, even if gloved or other barriers were used. Wash hands with soap and running water for at least 15 seconds and dry with disposable towels.

PRECAUTION: Proper Waste Disposal Anything contaminated with potentially infectious substances should be discarded in a sturdy plastic bag. Tie the bag and place it into a leakproof container where it will not be disturbed until picked up for appropriate disposal.

PRECAUTION: Protective Barriers When accidents happen on the job, it may seen natural to help your coworker without thinking of your own safety. However, when looking out for others, you must protect yourself. Avoid letting blood or body fluids visibly contaminated with blood contact your skin, eyes, nose, mouth, and clothing by using personal protective barriers such a gloves and a protective smock or apron. Even the goggles, gloves, and dust masks you may use on the job can help to protect you.

Whenever possible, a person with a minor injury should try to stop the bleeding themselves. If necessary, you may assist the person in applying pressure to the wound by using a barrier to avoid direct contact with the blood. Pull on a pair of disposable latex gloves, or other leakproof gloves. After assisting your coworker, discard your disposable gloves. Never reuse them. Heavy utility gloves can be cleaned and reused, but should be discarded if damaged. When removing gloves, be careful not to expose your skin to the glove exterior. Always wash your hands after removing gloves. In a true emergency, call for help while turning off any machinery that might have trapped the victim. If possible, another coworker should simultaneously notify the company’s first responders. First responders are trained to help the accident victim and to protect themselves against bloodborne diseases at the same time. When necessary, help the victim control bleeding AFTER protecting yourself with gloves. In certain situations you may even wish to put on safety goggles or other gear to provide an effective barrier. Once any bleeding is under control, keep the victim comfortable until the first responders arrive.

When CPR is needed, remember to protect yourself. Unprotected mouth-to-mouth resuscitation can be hazardous to your because the victim may have blood or bloody vomit in their mouth Give CPR only if you are trained to do so, and remember that current CPR training excludes mouth-to-mouth resuscitation, relying exclusively on chest compressions. Still, you can be prepared by keeping a pocket mask on hand to protect you from the victim’s saliva and body fluids. After the incident, a hazardous situation continues to exist until the workplace is properly cleaned of blood and body fluid.

PRECAUTION: Preventative Work Practices Some safety measures are just plain good sense! When working around areas that might be contaminated, keep your hands away from your face, especially your nose, mouth, and eyes. Be sure to wash your hands and remove any protective clothing before eating, drinking, smoking, applying cosmetics or lip balm, or handling contact lenses. A safe work environment is every worker’s responsibility. Whenever possible, attend to your own minor injuries and clean up after yourself. Place blood soaked tissues or other materials in a sealed plastic bag and discard. Be sure to bandage any cuts or sores you may have in order to protect yourself and to avoid smearing blood on work surfaces.

IF YOU ARE EXPOSED TO BLOOD If an exposure occurs, don’t panic. If you get blood or body fluids on your gloves, clothes, or shoes, remove them as soon as possible and place in a sealed plastic bag. Next, wash your skin with non-abrasive soap and water. Follow your company’s policy to decontaminate or dispose of the contaminated items. If you do get blood of body fluids on your skin, wash immediately with non-abrasive soap and water. Flush exposed mucous membranes with water. If these substances get in your eyes, immediately flush your eyes with running water at a sink or eyewash fountain. Report the incident immediately to your supervisor. If you are exposed to a potentially infectious substance, your employer can advise you about testing, counseling, and any other steps you may wish to take.

Summary You can protect yourself from bloodborne diseases by using common sense and following simple guidelines. Know where emergency kits and protective equipment are kept. Find out whether your company has trained emergency personnel and know how to contact them. Never take unnecessary risks. Yes, shut off machinery, sound the alarm, and do whatever you must to save a life. But don’t touch blood or body fluids without using gloves or some other protection. Use a face mask if you must perform mouth-to-mouth resuscitation, and don’t clean up blood or body fluids unless trained and authorized to do so. Know what to do before an emergency occurs. Preparation means prevention!
- Slides: 21